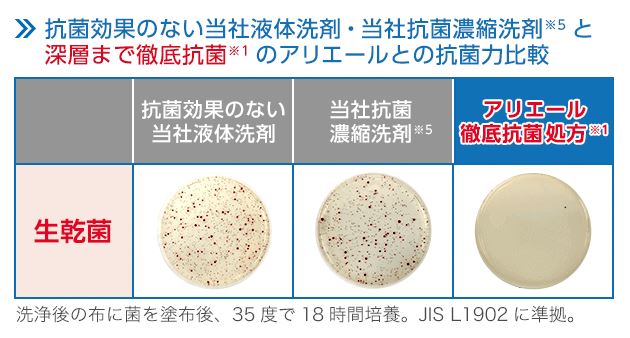
�[�w�܂œO��R�ۃe�N�m���W�[�̔閧

製品特長
[メーカー情報]![]() |
アリエールイオンパワージェルは、漂白剤なしで一発洗浄!※2 しかも洗濯槽の防カビ、干している時の抗菌、そして着用中の抗菌まで! アリエールで3ステップ抗菌※1
1.洗濯槽の防カビ!
干している最中の抗菌だけでなく、アリエール1本で洗濯槽の防カビも!
2.部屋干し中の抗菌!
部屋干し中の生乾き臭も抗菌防臭!
3.着用中まで抗菌防臭!
部屋干し中の生乾き臭も抗菌防臭!
※1 すべてのニオイ菌の増殖を抑えるわけではありません。
※2 2017年8月P&G調べ。汚れの度合いにより、汚れ落ちの程度は異なります。
1.一見きれいな洗い立てのタオル。使っているうちにニオイが戻ってくるのは、繊維の奥に菌が潜んでいるから。
2.P&Gの抗菌濃縮洗剤※5では、繊維の奥にまで根付いた菌※6を抑えることができず、ニオイの原因となる汚れを取りきれていませんでした。
3.アリエールは、繊維の奥に根付いた菌※6まで徹底抗菌※1。ニオイの元をしっかり抑え、ニオイ戻りを防ぎます。
![]() |
※1 すべてのニオイ菌の増殖を抑えるわけではありません。
※5 P&Gの抗菌濃縮洗剤。 ※6 除菌効果を示すものではありません。
![]() |
洗濯物からイヤな臭いが…それは洗濯槽のカビが原因かも。
洗濯槽の裏や奥は手入れもしづらく、洗っても洗っても落ちない衣類のニオイや汚れの原因になってしまいます。
![]() |
漂白剤なしでも一発洗浄※2
独自のイオンバランスで配合された3種類の界面活性剤が、頑固な汚れやニオイに効果的にアプローチ。漂白剤なしで一発洗浄!※2
※2 2017年8月P&G調べ。汚れの度合いにより、汚れ落ちの程度は異なります。